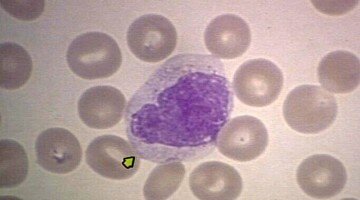
О чем могут сигнализировать повышенные моноциты в крови?

Что такое болезнь Верльгофа и как ее распознать
Болезнь Верльгофа относят к хроническим заболеваниям, которые наиболее часто проявляются у детей и женщин. Она протекает преимущественно волнообразно и характеризуется кровотечениями и подкожными кровоизлияниями. Это происходит по причине значительного снижения тромбоцитов в крови заболевшего, которые...
О чем могут сигнализировать повышенные моноциты в крови?
Кровяные тельца в крови делятся на красные и белые по их цвету под микроскопом. Самым многочисленным отрядом среди белых кровяных телец являются лейкоциты. Они отвечают за противодействие организма различным внешним агентам, попадающим в него. К...

Гиповолемия. Симптомы и причины. Классификация
Уменьшение общего количества крови, находящейся в сосудах человека, называется гиповолемией. В нормальном здоровом состоянии у мужчин объём жидкой крови колеблется от 65 мл/кг до 75 мл/кг, а плазмы – 36–42 мл/кг. У здоровых женщин показатели...

Классификация и типы гиперлипидемии
В крови человека растворено множество различных элементов, в том числе и жиры, которые называются липидами. Они входят в состав большинства гормонов и многих других активных веществ, а соответственно, играют значимую роль в организме. В том...

Признаки гипогликемии у взрослых и детей
Гипогликемия опасна тем, что при ней происходит значительное понижение глюкозного уровня, что как следствие приводит к кислородному голоданию организма. Это состояние грозит серьёзными нарушениями в работе многих органов, в том числе и клеток головного мозга....

Всё, что нужно знать о гипонатриемии
Гипонатриемией называют патологическое состояние организма, когда уровень натрия в крови снижается ниже 135 ммоль/л.